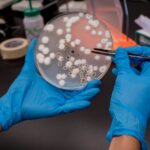
Blockchain in Supply Chain Transparency: Building Trust Through Technology

In today’s globalized economy, supply chains have become increasingly complex, involving multiple stakeholders across different regions. Ensuring transparency, traceability, and trust within these networks is a major challenge for businesses. This is where blockchain technology is emerging as a game-changer. By providing a secure and decentralized system for recording transactions, blockchain is transforming how supply chains operate and how information is shared.
At its core, Blockchain is a digital ledger that records transactions in a secure, transparent, and immutable manner. Each transaction is stored in a “block” and linked to the previous one, creating a chain that cannot be altered without consensus from the network. This structure ensures data integrity and eliminates the risk of tampering or fraud, making it highly suitable for supply chain applications.
One of the biggest advantages of blockchain in supply chains is enhanced traceability. Companies can track the journey of products from raw materials to the end consumer. This is particularly important in industries such as food, pharmaceuticals, and luxury goods, where authenticity and quality are critical. For example, blockchain can help identify the source of contamination in food products or verify the origin of high-value items.
Transparency is another key benefit. All participants in the supply chain can access a shared, real-time view of transactions. This reduces information asymmetry and improves collaboration among stakeholders. Companies like IBM are developing blockchain-based solutions that enable businesses to monitor supply chain activities with greater accuracy and efficiency.
Fraud prevention and security are significantly improved with blockchain. Traditional supply chains often rely on paper-based records or centralized databases, which can be vulnerable to manipulation. Blockchain’s decentralized nature ensures that data is distributed across multiple nodes, making it highly resistant to cyberattacks and unauthorized changes.
Efficiency and cost reduction are also important outcomes of blockchain adoption. By automating processes through smart contracts self-executing agreements coded on the blockchain—businesses can reduce the need for intermediaries and manual verification. This streamlines operations, reduces delays, and lowers administrative costs.
In India, blockchain is gradually being explored to improve supply chain transparency in sectors such as agriculture, logistics, and pharmaceuticals. With increasing focus on digital transformation, businesses are recognizing the potential of blockchain to enhance trust and accountability in their operations.
Sustainability is another area where blockchain can make a significant impact. Consumers are becoming more conscious about the environmental and social impact of products. Blockchain enables companies to provide verifiable information about sourcing, production practices, and carbon footprints. This level of transparency helps build consumer trust and supports responsible business practices.

Despite its advantages, the adoption of blockchain in supply chains faces several challenges. High implementation costs, lack of standardization, and limited technical expertise can hinder widespread adoption. Additionally, integrating blockchain with existing systems requires careful planning and investment.
Scalability is another concern, as blockchain networks must handle large volumes of transactions efficiently. Ongoing advancements in technology are addressing these issues, making blockchain more practical for large-scale applications.
The future of blockchain in supply chain transparency looks promising. As technology evolves and adoption increases, more industries are expected to leverage its capabilities. Collaboration between businesses, governments, and technology providers will be essential to unlock its full potential.
In conclusion, blockchain is revolutionizing supply chain transparency by providing a secure, efficient, and trustworthy system for managing data. By enhancing traceability, reducing fraud, and improving collaboration, it is helping businesses build more resilient and accountable supply chains. As organizations continue to embrace digital innovation, blockchain will play a crucial role in shaping the future of global trade and logistics.